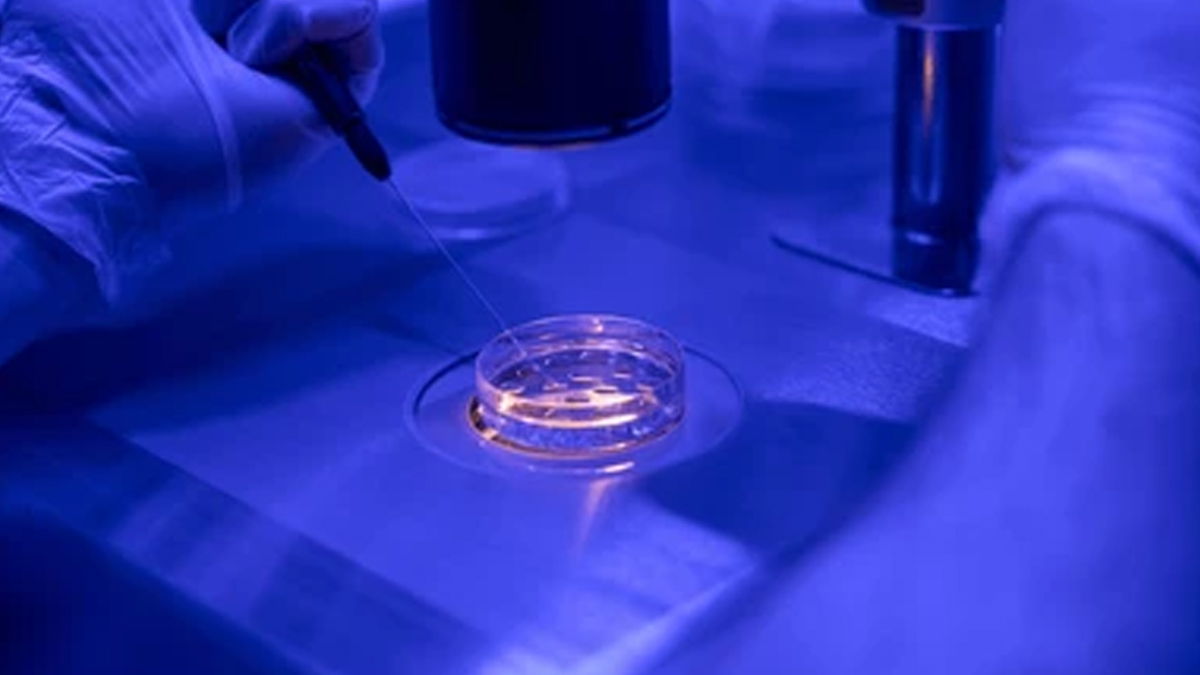
embryo-selection-by-AI

In Vitro Fertilisation (IVF) can be a physically and mentally demanding journey. When undergoing an IVF process, embryo selection is one of the most important steps. Usually, an embryologist chooses the embryo based on how it looks under a microscope, but even with the most expertise, this method cannot be foolproof. In today’s era of Artificial Intelligence (AI), choosing an embryo using this technology has been a game changer.
Table of Content:-
We spoke to Dr Rohan Palshetkar, Consultant IVF Specialist, Bloom IVF, Palshetkar Patil Nursing Home, Opera House, Mumbai, who explained how AI in embryo selection aims to revolutionise IVF success rates.
What AI Brings to Embryo Selection

"When you’re going through an IVF process, usually multiple embryos are formed, but not all of them have the same chance of producing a successful pregnancy. Selecting the best and most viable embryo gives you the best chance of a pregnancy," said Dr Palshetkar.
Usually, the embryologist looks at various factors, such as the number of cells and the appearance of the cytoplasm and the embryo. While useful and helpful, these judgements are subjective and cannot always predict success.
Also Read: KhushKhabriWithIVF: Fresh Vs Frozen Embryo Transfer, Which Is Better?
How AI Analyses Embryos Differently
AI can learn from large amounts of data and make smart predictions. Humans can also do that, but AI can do this faster and more consistently in the IVF process.” The AI systems look at the timelapse images and videos of an embryo's development. The system analyses embryos and compares them to what outcomes they can give us. These outcomes include whether a pregnancy has occurred or a healthy baby was born,” explained Dr Palshetkar.
Based on this AI scores or ranks the embryos helping us doctors choose the best embryo and giving you the highest chance of pregnancy. In addition, AI keeps looking at more and more images and keeps evolving further.
Benefits for Patients: Better Outcomes, Fewer Cycles

“AI in IVF helps patients by improving the chances of achieving a pregnancy and going on to deliver a healthy baby. In addition, patients require few IVF cycles to get pregnant and there is a lower risk of twins because when we know which embryo is the best, we can confidently select one embryo and put it inside the uterus. This means that there is less stress, fewer medications and faster results for the couples trying to go through IVF,” added Dr Palshetkar.
According to a 2024 study, AI tools are efficient and provide consistent results across all laboratories. Additionally, these systems might uncover new relationships among various embryo traits. They also deliver considerable economic advantages to healthcare systems.
Also Read: Which IVF Cycle Is Right for You? Expert Shares the Different Types of Protocol for Better Health
The Future: Personalised Fertility Care
AI is not only revolutionising the selection of embryos, but some systems are also taking into account your own medical history to give personalised recommendations. This is going to be the future where precision medicine is going to take over and that’s going to be tailor-made treatment plans specifically for you.
Message From The Expert
Dr Palshetkar shared, “AI won’t replace your doctor. It will be an assistant to help improve your treatment cycle. The doctors and embryologists make the final decision with more information and confidence than ever before. The integration of AI in fertility care is one of the most exciting advancements in today’s era. It combines doctors' expertise and technology to help couples achieve their dream of parenthood.”
[Disclaimer: This article contains information provided by an expert and is for informational purposes only. Hence, we advise you to consult your professional if you are dealing with any health issue to avoid complications.]
Also watch this video
How we keep this article up to date:
We work with experts and keep a close eye on the latest in health and wellness. Whenever there is a new research or helpful information, we update our articles with accurate and useful advice.
Current Version